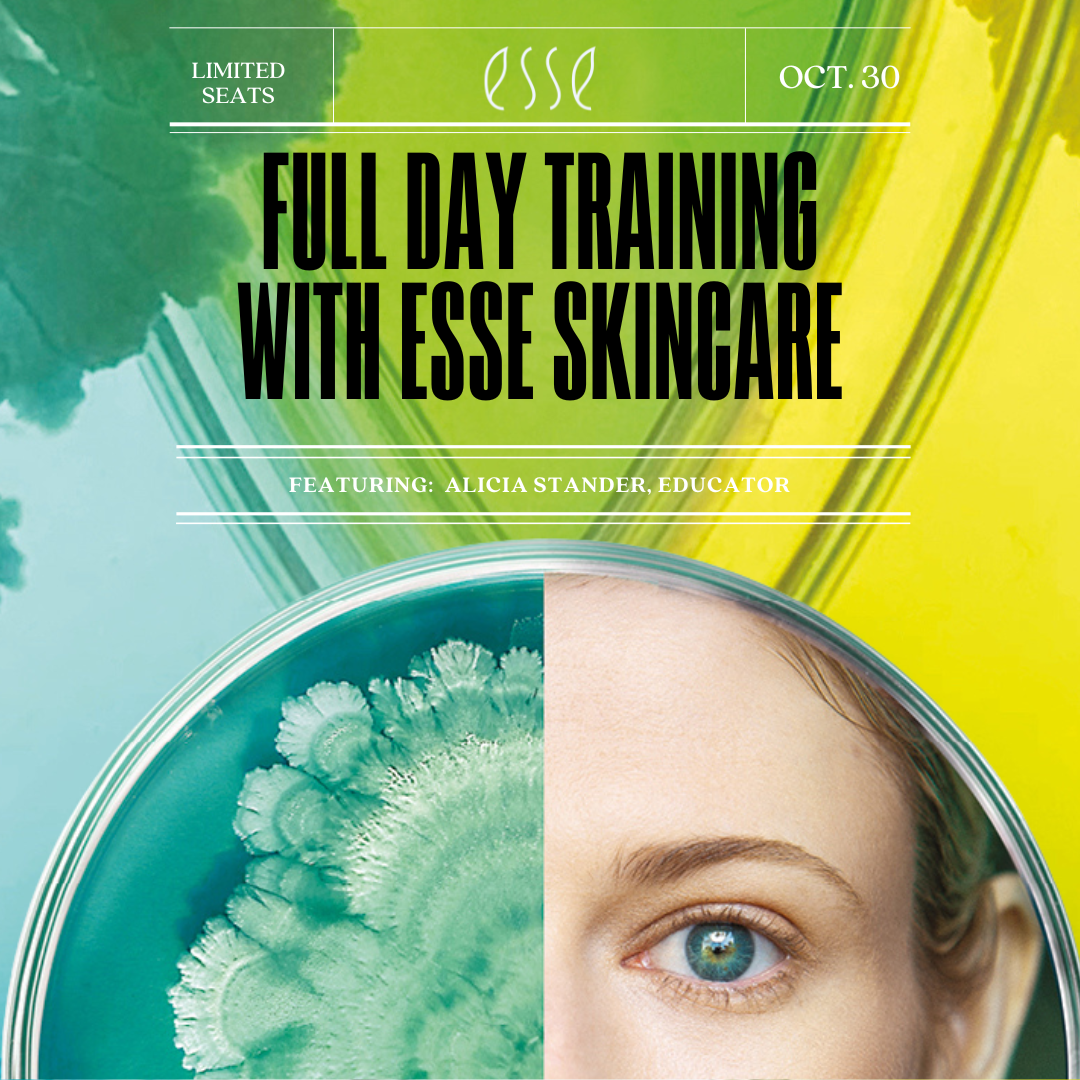

Collections
-

Esse Skin Care
Esse Skin Care
-

Esthetic Accessories and Implements
Esthetic Accessories and Implements
-

Esthetic Furniture and Equipment
Esthetic Furniture and Equipment